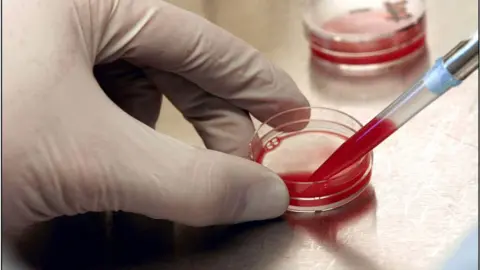
Getty Images blood tests

New test hope for liver disease in dogs
 Getty Images
Getty ImagesVets in Edinburgh have developed a blood test that quickly identifies early signs of liver disease in dogs.
The test, which is based on insights from human patients, could help vets begin treating sick animals earlier, say researchers.
It works by tracking levels of the blood molecule miR-122, a known marker of liver disease in humans.
Current diagnosis in dogs is based on biopsies, which are expensive and can lead to complications.
Vets based at the University of Edinburgh's Royal (Dick) School of Veterinary Studies teamed up with medical doctors to look at miR-122 in 250 dogs.
'Rapid diagnosis'
They found high levels of the molecule in the animals with liver disease compared with healthy dogs.
Getty Images
Getty ImagesThe team is to launch a testing kit to help vets worldwide following the study, published in the Journal of Veterinary Internal Medicine.
Lead researcher Prof Richard Mellanby, from The Hospital for Small Animals at Edinburgh University, said: "We have found a specific, sensitive and non-invasive way to detect liver damage in dogs.
"We hope that our test will greatly improve outcomes by allowing vets to make rapid and accurate diagnosis."
Dr James Dear, from Edinburgh University's Centre for Cardiovascular Science and an NHS doctor who co-led the study, added: "I am delighted that the blood test we developed to improve the diagnosis of liver disease in humans can be used to help dogs too."
